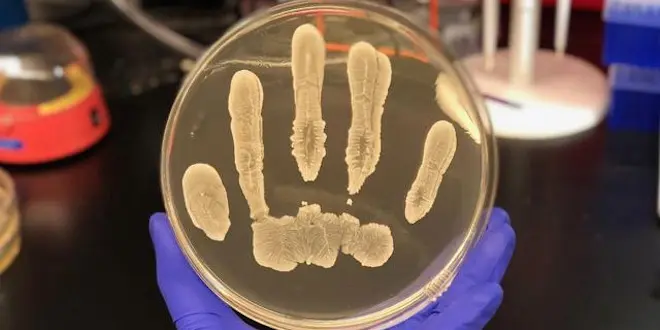

Sur notre peau, des bactéries qui combattent le cancer ?
Une souche de staphylocoque produit une molécule qui semble limiter, in vitro et chez la souris, le risque d’apparition de certaines tumeurs de la peau.
Par La rédaction d'Allo Docteurs
Mis à jour le
Le dangereux staphylocoque doré (S. aureus) n’est pas le seule représentant de la grande famille des staphylocoques. Sur une peau saine, ses cousins S. epidermidis, S. hominis et quelques autres se développent en harmonie avec de nombreuses autres espèces de bactéries. Défendant leur cher territoire, certaines empêchent l’invasion de bactéries pathogènes. C’est ainsi que nos epidermidis mènent la vie dure aux menaçantes aureus, à grands renforts de molécules qui les empoisonnent spécifiquement.
En cherchant à mieux caractériser ces molécules toxiques, des chercheurs nord-américains ont fait "une découverte inattendue" : S. epidermidis produit également une molécule, 6-HAP, qui posséde un profil voisin de l’adénine, l’une des quatre bases fondamentales de l’ADN.
Une molécule anti-cancer
Les chercheurs se sont alors demandés si la présence de 6-HAP pouvait entraver le processus de duplication de l'ADN, et donc de la réplication des cellules. In vitro, le phénomène a bel et bien été observé sur certaines catégories de cellules cancéreuses, qui voyaient ainsi leur prolifération stoppée net. La plupart des autres cellules étudiées disposaient elles de mécanismes leur permettant d'ignorer les 6-HAP.
L’expérience a ensuite été poussée plus loin. Sur la peau de souris de laboratoire, les chercheurs ont fait proliférer soit des S. epidermidis producteurs de 6-HAP, soit des S. epidermidis incapables d’exprimer la molécule. Les animaux ont ensuite été exposés à de fortes doses de rayons ultraviolets. Au terme de plusieurs semaines d’expérience, le premier groupe avait développé un nombre de tumeurs cutanées très significativement inférieur au second groupe.
"[La substance identifiée] tue plusieurs types de cellules cancéreuses, mais ne semble pas être toxique pour les cellules normales", a commenté dans un communiqué Richard Gallo, co-auteur des travaux.
Des résultats surprenants avec le 6-HAP administré en intraveineuse
Une expérience analogue, avec injection de 6-HAP en intraveineuse, a eu des effets similaires. "Les souris qui ont reçu des injections intraveineuses de 6-HAP toutes les 48 heures sur une période de deux semaines n'ont subi aucun effet toxique apparent. Des cellules de mélanomes leur ont été transplantées. Le volume des tumeur était inférieur de 50% par rapports aux souris témoins [qui n’avaient pas reçu l’injection]", détaillent les chercheurs.
Les auteurs insistent sur le fait que d'autres études restent nécessaires pour valider leurs observations, et si celles-ci peuvent être extrapolées à l’homme. En l’état, il n’est pas possible de savoir si la molécule 6-HAP pourrait être utilisée pour prévenir ou traiter les cancers, ou si l’absence de S. epidermidis productrices de 6-HAP sur la peau humaine est corrélée avec un risque plus élevé de mélanomes malins.
la rédaction d’Allodocteurs.fr
Source : Teruaki Nakatsuji et al. "A commensal strain of Staphylococcus epidermidis protects against skin neoplasia", Science Advances, 4(2) eaao4502, 28/02/2018. doi:10.1126/sciadv.aao4502










